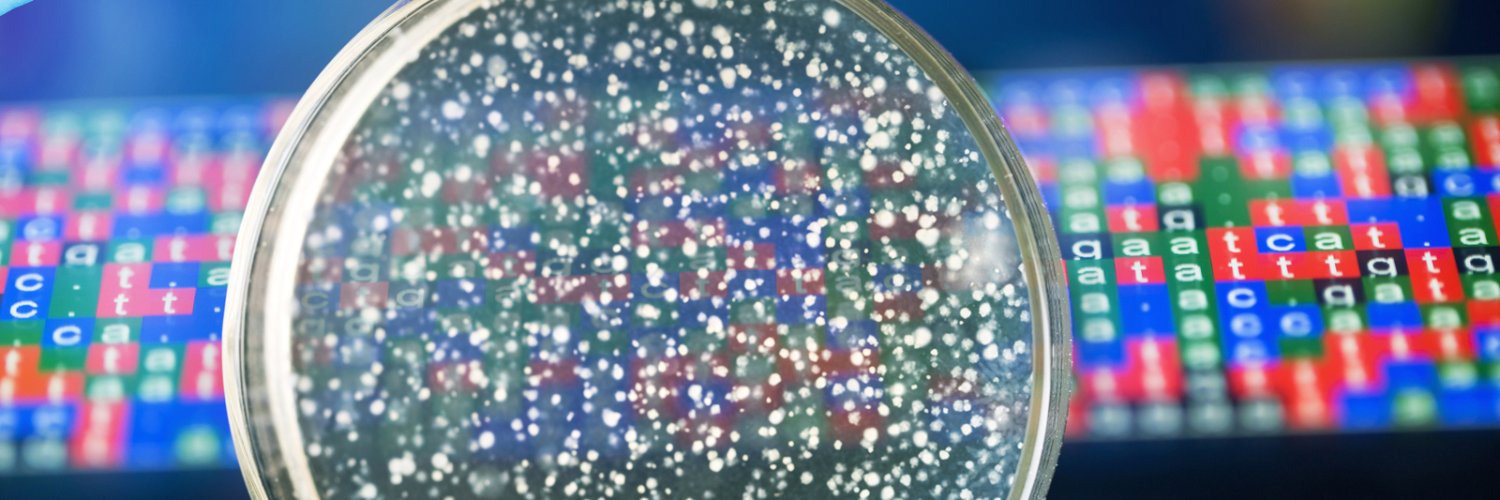
Caitlin Falconer banner

Caitlin Falconer
43 posts

Caitlin Falconer
@caitlin_f
Bioinformatician, pharmacist and PhD candidate. Interest in microbial genomics, antibiotic resistance and potted plants.
Brisbane, Queensland Katılım Nisan 2012
315 Takip Edilen111 Takipçiler

Sooo ... I’m here stimulating the coffee industry and a wild animal appears in the art.
Anyone know what it is?
#coffee #cafe #Australia

Brisbane, Queensland 🇦🇺 English
Caitlin Falconer retweetledi

The Aged Care National Antimicrobial Prescribing Survey is an annual survey of antimicrobial prescribing practices in Australian aged care homes and helps demonstrate compliance with the Aged Care Quality Standards. Participate by registering at naps.org.au.

English
Caitlin Falconer retweetledi

Was just talking coronavirus genomics, @CovidGenomicsUK and whether there's more than one strain of SARS-CoV-2 (hint: there isn't) on @BBCRadio4 @BBCr4today bbc.co.uk/sounds/play/li… (scroll to 8:35am!).
English
Caitlin Falconer retweetledi

Join me in stopping the spread of COVID-19! Download COVIDSafe, an app from the Australian Government. #COVID19
#coronavirusaustralia #stayhomesavelives covidsafe.gov.au
English
Caitlin Falconer retweetledi

@adm_stewart I had the same thought about the effect this might have in aged care too
English

It would be interesting to look at HAIs pre and post COVID-19. I don’t think I’ve ever seen HCWs wash their hands so frequently! #CollateralBenefit
English
Caitlin Falconer retweetledi

Correct technique to wash your hands for proper disinfection. #CoronavirusOutbreakindia #CoronaVirusUpdate #COVID #CoronaVirusUpdate
English
Caitlin Falconer retweetledi

With everything happening with #COVIDー19 I would like to encourage doing practices that boost your mental health & counter the stress associated during this time.
Below will be a few tips that may help you!
#MentalHealth #coronavirus #coronavirusaustralia

English

@PlasmidsMate And every single time the line of code finally does work.
Every. Single. Time.
GIF
English

Every single time the line of code I wrote doesn't work.
Every. 😐 Single.😐 Time. 😐😂
#PhDchat #science #AcademicChatter #Bioinformatics
GIF
English
Caitlin Falconer retweetledi

HUGE NEWS:
"10 years after vaccination was introduced, we detected no HPV16/18 infections in 16-18 yearolds (0% of n=584)"
HPV 16/18 cause ~70% of cervical cancer
That's an ~amazing~ result
assets.publishing.service.gov.uk/government/upl…

English
Caitlin Falconer retweetledi

Phenomenal new way to do science. it makes current publication system to look prehistoric! Please get a cup of tea or coffee & take some time to go over this report of the #nCoV2019 #coronavirus outbreak. nextstrain.org/narratives/nco… Fantastic work by @richardneher @trvrb @firefoxx66
English
Caitlin Falconer retweetledi

Why are so many elderly people taking antibiotics? bit.ly/350sn70
English
Caitlin Falconer retweetledi

Another reason why we need clinical #pharmacists embedded in #AgedCare facilities. Almost 10% residents receiving antimicrobials, 65% with no clear indication, 28% continued for > 6 months. #AntimicrobialStewardship #Geriatrics #SHPAGeri
Australian Prescriber@AustPrescriber
Why are so many elderly people taking antibiotics? bit.ly/350sn70
English
Caitlin Falconer retweetledi

"tracked.. ten MGE-bearing plasmids in all 2,173 genomes... transfer of plasmids between patients independent from bacterial transmission..2 instances of likely plasmid transfer across genera within individual patients" from @DariaVanTyne, @vscooper and colleagues
bioRxiv Microbiology@biorxiv_micrbio
Comprehensive analysis of horizontal gene transfer among multidrug-resistant bacterial pathogens in a single hospital biorxiv.org/cgi/content/sh… #biorxiv_micrbio
English
Caitlin Falconer retweetledi

The 2018 Aged Care National Antimicrobial Prescribing Survey (>400 ACHs, >20,000 residents) results suggest targets for quality improvement: assessment & diagnosis of infection, topical ABX use, prophylactic ABX use, broad-spectrum ABX use, & more #AAW19 - bit.ly/2NLc603

English
Caitlin Falconer retweetledi

Caitlin Falconer retweetledi

It's Antibiotic Awareness Week next week! Take a look at new #AAW2019 fact-sheets/posters from @NCAS_Aus @Guidance_Group & our collaborators: beta-lactam allergies; antibiotic duration in hospitals & the community; & antibiotic use in aged care!: ncas-australia.org/education

English

